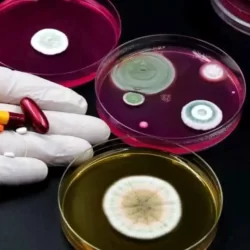

لم ينتظر المدرب البرتغالي خورخي جيسوس طويلًا لرصد نقاط الضعف في تشكيل نادي النصر، إذ وضع مركز الظهير الأيسر على رأس أولوياته، في ظل معاناة الفريق الدفاعية في هذا المركز الموسم الماضي. وأشارت صحيفة “الشرق الأوسط” إلى أن جيسوس رشح 4 أسماء لتعزيز الجبهة اليسرى، من بينها لاعبان ينشطان في الدوريين الإنجليزي والألماني، دون الكشف عن هويتهما.
وبرز اسم سعد الناصر، ظهير التعاون البالغ من العمر 24 عامًا، ضمن القائمة المقترحة من قبل المدرب البرتغالي، بعدما شارك في 60 مباراة بالدوري السعودي، سجل خلالها 4 أهداف وقدم 7 تمريرات حاسمة. كما تضم قائمة جيسوس اسم آيرتون لوكاس، لاعب فلامنغو البرازيلي، الذي سبق له تمثيل منتخب بلاده في مناسبتين دوليتين.
ورغم ذلك، لم يبرم النصر حتى الآن سوى صفقة واحدة لتعزيز هذا المركز، بضم عبد الملك الجابر صاحب الـ21 عامًا من الدوري البوسني. وفي حال تعثر التعاقد مع الأسماء الأجنبية، يُتوقع أن يعتمد جيسوس على عبد الإله الخيبري في الجبهة اليسرى خلال الموسم الجديد.